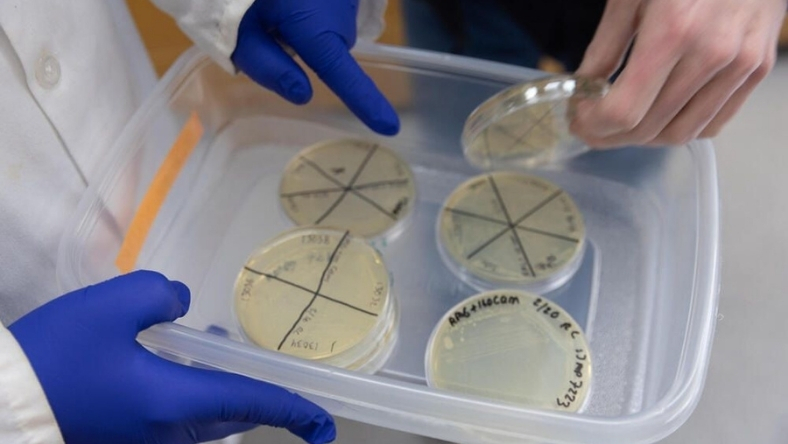
Laboratory researchers examining petri dishes with experimental samples

INNOVATION
DARPA's Fleetwood program funds next-gen catalysts to convert lignin from crop waste into petroleum-replacing chemicals
25 Mar 2026

Every year, American farms, timber operations, and paper mills discard or burn gigatons of lignin, the carbon-rich molecule that gives plants their structure. For decades, scientists have known it could substitute for petroleum-derived chemicals in plastics, adhesives, and composites. The economics, however, never worked. DARPA thinks it knows why, and believes it can fix it.
Launched in February 2026, the agency's Fleetwood program funds the development of catalysts capable of breaking down lignin from mixed, real-world biomass and converting it into commercially useful products. The defense rationale is blunt: supply chains for materials used across US military systems rely heavily on aromatic chemicals derived from petroleum, making them vulnerable to geopolitical shocks. The Army, Navy, Air Force, Marine Corps, and the Defense Threat Reduction Agency have all signaled interest in what Fleetwood might deliver.
The program runs on two parallel tracks. The first targets catalysts that can handle heterogeneous biomass reliably, the kind found on actual farms rather than in controlled laboratory conditions. The second focuses on converting processed lignin into specific, high-value outputs. Program manager William Mounfield described the goal as achieving atomic-level precision, turning what has long been waste into a domestically derived, on-demand resource. He also suggested that success could support a new generation of modular biorefineries operating profitably in rural communities.
That last point carries commercial weight beyond the Pentagon. Cellulosic biofuel producers have long treated lignin as a disposal cost rather than a revenue stream. If Fleetwood's catalysts change that calculus, the economics of advanced biofuel production could improve materially, closing a gap that has frustrated the sector for years.
An Industry Day was held on March 12, 2026 in Arlington, Virginia. A formal funding solicitation through SAM.gov is expected shortly.
The program's ambitions are considerable, and DARPA's track record in translating materials science into deployable technology is uneven. Still, the combination of defense procurement interest and potential commercial spillovers gives Fleetwood a clearer path to scale than most academic lignin research has managed. Whether catalytic chemistry can finally make plant waste pay is the question. The agency, at least, is willing to fund the answer.
25 Mar 2026
20 Mar 2026
16 Mar 2026
10 Mar 2026
INNOVATION
25 Mar 2026

INNOVATION
20 Mar 2026

INSIGHTS
16 Mar 2026
By submitting, you agree to receive email communications from the event organizers, including upcoming promotions and discounted tickets, news, and access to related events.